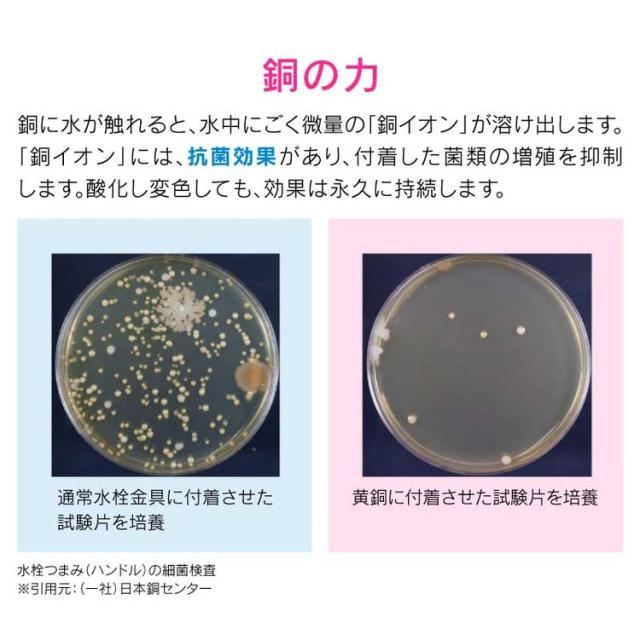

カクダイ 台所用 流し用 ゴミカゴとフタセット 銅製 GA-PB028 日本製 燕三条 抗菌(1セット)[水切りネット 三角コーナー]
Pontaパス特典
サンキュー配送
9,077円(税込)
0ポイント(1%)
商品説明

商品に関するお電話でのお問合せは、下記までお願いいたします。
カクダイ:06-6538-1121
GAONA:03-3552-0981
リニューアルに伴い、パッケージ・内容等予告なく変更する場合がございます。予めご了承ください。
【ブランド】
GAONA
【発売元、製造元、輸入元又は販売元】
カクダイ
【カクダイ 台所用 流し用 ゴミカゴとフタセット 銅製 GA-PB028 日本製 燕三条 抗菌の商品詳細】
●キッチンのシンク用の排水プレートと浅型ゴミカゴのセット。
●銅イオンの抗菌効果で、ヌメリや臭いを防ぎます。
●ゴミカゴ内のゴミを隠してスッキリ見せ、蓋の穴からゴミをバスケットに素早く収納できます。
●マンションやアパートなどの賃貸住宅での交換にオススメです。
●開口部が大きいため、水が流れやすいです。
●浅型バスケットなので、こまめなゴミ捨てでいつも清潔です。
品番:4972353803989
【セット詳細】
| 排水プレート、浅型ゴミカゴ |
【カクダイ 台所用 流し用 ゴミカゴとフタセット 銅製 GA-PB028 日本製 燕三条 抗菌の原材料】
| 銅 |
【規格概要】
| 外寸:(プレート)直径144*高さ17mm・(ゴミカゴ)直径144*高さ44.5mm 取付可能排水口内径:145mm(購入前にはサイズを必ず確認してください) カクダイ品番:452-016と451-208のセット品 材質:銅 |
【注意事項】
・使用を重ねるうちに黒ずんでいき、しだいに薄青みがかった皮膜に変色しますが、銅イオンの殺菌効果は変わりません。
カクダイ 台所用 流し用 ゴミカゴとフタセット 銅製 GA-PB028 日本製 燕三条 抗菌に関する詳細なお問合せは下記までお願いします
カクダイ
550-0012 大阪府大阪市西区立売堀1丁目4番4号 ※お問合せ番号は商品詳細参照
ショップ名 爽快ドラッグ
銅イオンの殺菌効果でヌメリやにおいを防ぐ
レビュー
商品の評価:



-点(0件)








